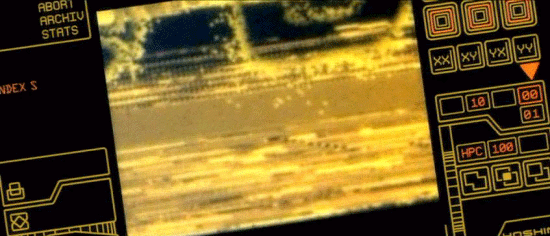

|
DANTE 01 -- ILLUSTRATED SCREENPLAY & SCREENCAP GALLERY |
|
LAMBERT WILSON -- SAINT-GEORGES LINH-DAN PHAM -- ELISA SIMONA MAICANESCU -- PERSEPHONE DOMINIQUE PINON -- CESAR BRUNO LOCHET -- BOUDDHA FRANCOIS LEVANTAL -- LAZARE GERALD LAROCHE -- CHARON
|